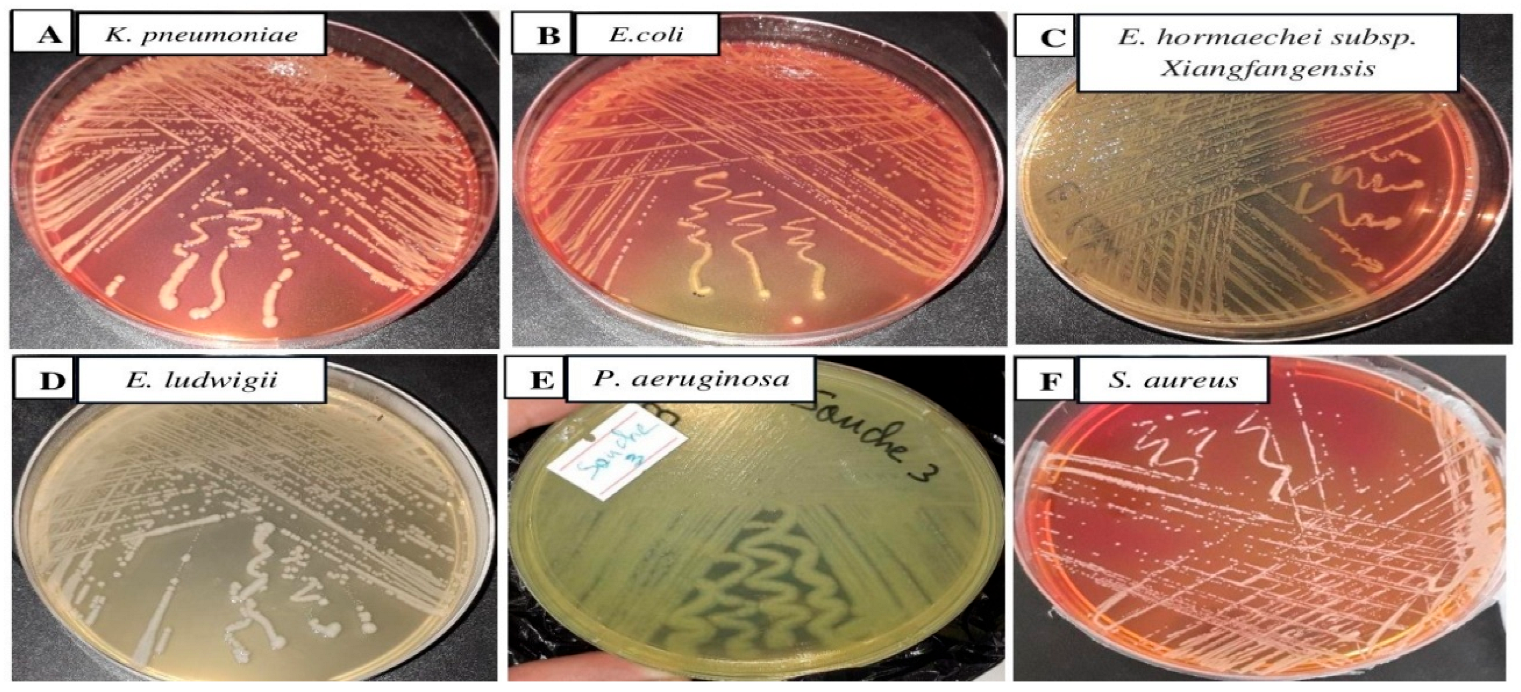
Antibiotics 14 00471 g002
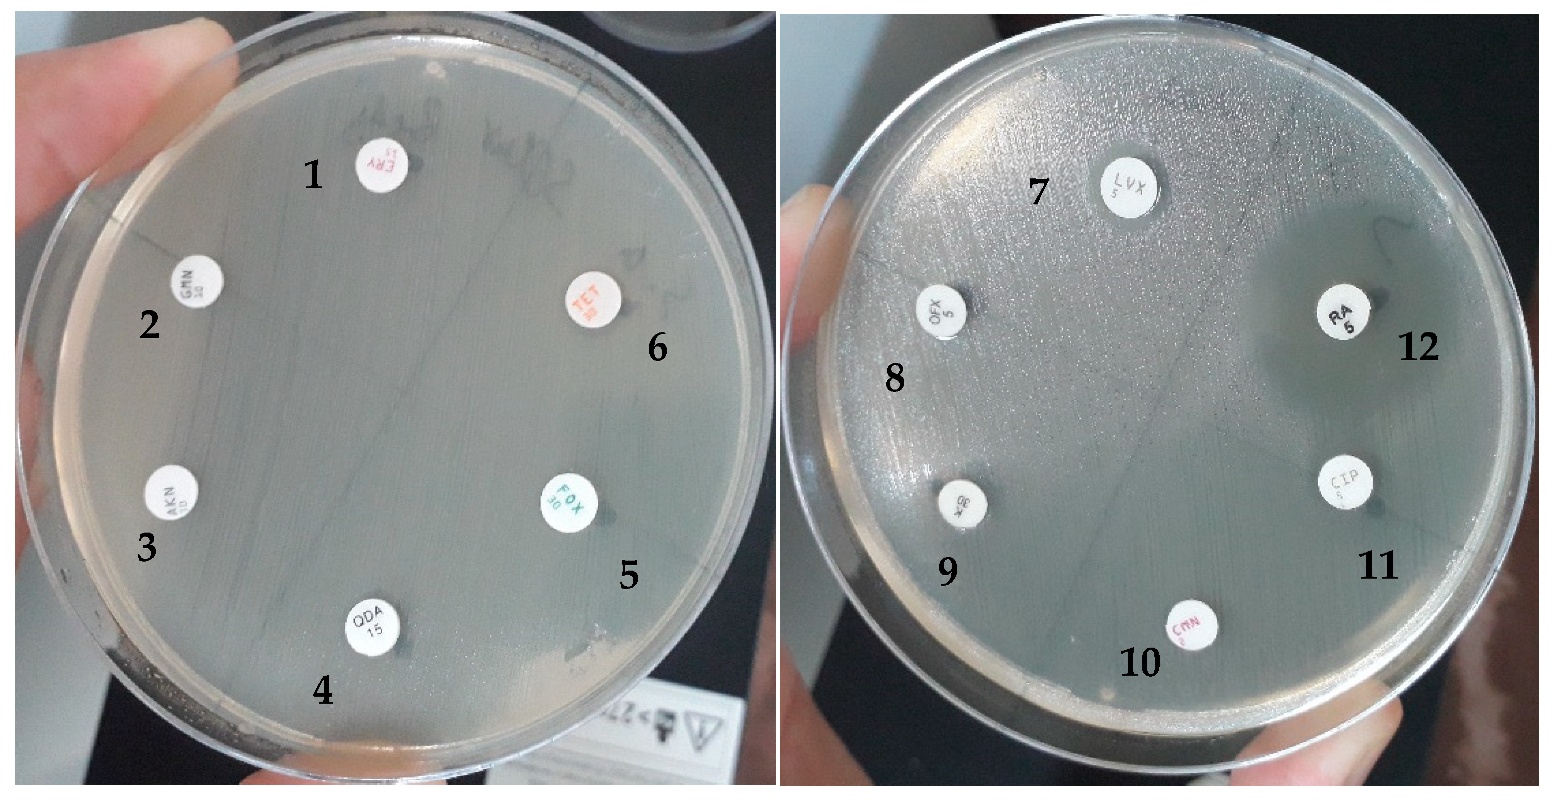
Antibiotics 14 00471 g009

Use of Haloxylon scoparium Against Multidrug-Resistant Bacteria from Urinary Tract Infections
Abstract
1. Introduction
2. Results
2.1. Polyphenol Compound Profile of Methanol Extract by HPLC-DAD
2.2. Acute Oral Toxicity of Methanolic Extract
2.3. Antibacterial Assays of H. scoparium Extracts
2.3.1. Isolation of Bacterial Strains
2.3.2. Biochemical Investigation
2.3.3. Isolation and Identification of Bacterial Isolates
- Isolate 1 (Klebsiella pneumoniae)GCTAACACATGCAAGTCGAGCGGTAGCACAGAGAGCTTGCTCTCGGGTGACGAGCGGCGGACGGGTGAGTAATGTCTGGGAAACTGCCTGATGGAGGGGGATAACTACTGGAAACGGTAGCTAATACCGCATAATGTCGCAAGACCAAAGTGGGGGACCTTCGGGCCTCATGCCATCAGATGTGCCCAGATGGGATTAGCTAGTAGGTGGGGTAACGGCTCACCTAGGCGACGATCCCTAGCTGGTCTGAGAGGATGACCAGCCACACTGGAACTGAGACACGGTCCAGACTCCTACGGGAGGCAGCAGTGGGGAATATTGCACAATGGGCGCAAGCCTGATGCAGCCATGCCGCGTGTGTGAAGAAGGCCTTCGGGTTGTAAAGCACTTTCAGCGGGGAGGAAGGCGTTGAGGTTAATAACCTTGGCGATTGACGTTACCCGCAGAAGAAGCACCGGCTAACTCCGTGCCAGCAGCCGCGGTAATACGGAGGGTGCAAGCGTTAATCGGAATTACTGGGCGTAAAGCGCACGCAGGCGGTCTGTCAAGTCGGATGTGAAATCCCCGGGCTCAACCTGGGAACTGCATTCGAAACTGGCAGGCTAGAGTCTTGTAGAGGGGGGTAGAATTCCAGGTGTAGCGGTGAAATGCGTAGAGATCTGGAGGAATACCGGTGGCGAAGGCGGCCCCCTGGACAAAGACTGACGCTCAGGTGCGAAAGCGTGGGGAGCAAACAGGATTAGATACCCTGGTAGTCCACGCCGTAAACGATGTCGATTTGGAGGTTGTGCCCTTGAGGCGTGGCTTCCGGAGCTAACGCGTTAAATCGACCGCCTGGGGAGTACGGCCGCAAGGTTAAAACTCAAATGAATTGACGGGGGCCCGCACAAGCGGTGGAGCATGTGGTTTAATTCGATGCAACGCGAAGAACCTTACCTGGTCTTGACATCCACAGAACTTTCCAGAGATGGATTGGTGCCTTCGGGAACTGTGAGACAGGTGCTGCATGGCTGTCGTCAGCTCGTGTTGTGAAATGTTGGGTTAAGTCCCGCAACGAGCGCAACCCTTATCCTTTGTTGCCAGCGGTTCGGCCGGGAACTCAAAGGAGACTGCCATGATAACTGGAGGAAGGTGGGGATGACGTCAGTCATCATGGCCCTTACGACAGGGCTACCACGTGCTACATGGCATTAC
- b.
- Isolate 2 (Escherichia coli)GGCAGAAAGCTTGCTGTTTTTGCTGACGAGTGGCGGACGGGTGAGTAATGTCTGGGAATCTGCCTGATGGAGGGGGATAACTACTGGAAACGGTGGCTAATACCGCATAACGTCTCCGGACCAAAGAGGGGGATCTTCGGACCTCTTGCCATCGGATGAGCCCATATGGGATTAGCTAGTAGGTGGGGTAACGGCTCACCTAGGCGACGATCCCTAGCTGGTCTGAGAGGATGACCAGCCACACTGGAACTGAGACACGGCCCAGACTCCTACGGGAGGCAGCAGTGGGGAATATTGCACAATGGGCGCAAGCCTGATGCAGCCATGCCGCGTGTATGAAGAAGGCCTTCGGGTTGTAAAGTACTTTCAGCGGGGAGGAAGGGAATAAAGTTAATACCTTTGCTCATTGACGTTACCCGCAGAAGAAGCACCGGCTAACTCCGTGCCAGCAGCCGCGGTAATACGGAGGGTGCAAGCGTTAATCGGAATTACTGGGCGTAAAGCGCACGCAGGCGGTTTGTTAAGTCAGATGTGAAATCCCCGGGCTCAACCTGGGAACTGCATCTGATACTGGCTGGCTTGAGTCTCGTAGAGGGGGGTAGAATTCCATGTGTAGCGGTGAAATGCGTAGAGATCTGGAGGAATACCGGTGGCGAAGGCGGCCCCCTGGACAAAGACTGACGCTCAGGTGCGAAAGCGTGGGGAGCAAACAGGATTAGATACCCTGGTAGTCCACGCTGTAAACGATGTCGACTTGGAGGTTGTGCCCTTGAAGCGTGGCTTCCGGAGCTAACGCGTTAAGTCGACCGCCTGGGGAGTACGGCCGCAAGGTTAAAACTCAAATGAATTGACGGGGGCCCGCACAAGCGGTGGAGCATGTGGTTTAATTCGATGCAACGCGAAGAACCTTACCTGCTCTTGACATCCACCGAATTT
- c.
- Isolate 3 (Pseudomonas aeruginosa)GGCAGCCTACACATGCAAGTCGAGCGGATGAAGGGAGCTTGCTCCTGGATTCAGCGGCGGACGGGTGAGTAATGCCTAGGAATCTGCCTGGTAGTGGGGGATAACGTCCGGAAACGGGCGCTAATACCGCATACGTCCTGAGGGAGAAAGTGGGGGATCTTCGGACCTCACGCTATCAGATGAGCCTAGGTCGGATTAGCTAGTTGGTGGGGTAAAGGCCTACCAAGGCGACGATCCGTAACTGGTCTGAGAGGATGATCAGTCACACTGGAACTGAGACACGGTCCAGACTCCTACGGGAGGCAGCAGTGGGGAATATTGGACAATGGGCGAAAGCCTGATCCAGCCATGCCGCGTGTGTGAAGAAGGTCTTCGGATTGTAAAGCACTTTAAGTTGGGAGGAAGGGCAGTAAGTTAATACCTTGCTGTTTTGACGTTACCAACAGAATAAGCACCGGCTAACTTCGTGCCAGCAGCCGCGGTAATACGAAGGGTGCAAGCGTTAATCGGAATTACTGGGCGTAAAGCGCGCGTAGGTGGTTCAGCAAGTTGGATGTGAAATCCCCGGGCTCAACCTGGGAACTGCATCCAAAACTACTGAGCTAGAGTACGGTAGAGGGTGGTGGAATTTCCTGTGTAGCGGTGAAATGCGTAGATATAGGAAGGAACACCAGTGGCGAAGGCGACCACCTGGACTGATACTGACACTGAGGTGCGAAAGCGTGGGGAGCAAACAGGATTAGATACCCTGGTAGTCCACGCCGTAAACGATGTCGACTAGCCGTTGGGATCCTTGAGATCTTAGTGGCGCAGCTAACGCGATAAGTCGACCGCCTGGGGAGTACGGCCGCAAGGTTAAAACTCAAATGAATTGACGGGGGCCCGCACAAGCGGTGGAGCATGTGGTTTAATTCGAAGCAACGCGAAGAACCTTACCTGGCCTTGACATGCTGAGAACTTTCCAGAGATGGATTGGTGCCTTCGGGAACTCAGACACAGGTGCTGCATGGCTGTCGTCAGCTCGTGTCGTGAGATGTTGGGTTAAGTCCCGTAACGAGCGCAACCCTTGTCCTTAGTTACCAGCACCTCGGGTGGGCACTCTAAGGAGACTGCCGGTGACAACCGGAGGAAGGTGGGGATGACGTCAAGTCATCTGGCCCTTACGGCAGGGCTACCACGTGCTACATGGTCGGTACAAGGGTTGCCAGCCGCGAG
- d.
- Isolate 4 (Enterobacter hormaechei subsp. xiangfangensis)ACAGGCAAGCAGCTTGCTGCTTCGCTGACGAGTGGCGGACGGGTGAGTAATGTCTGGGAAACTGCCTGATGGAGGGGGATAACTACTGGAAACGGTAGCTAATACCGCATAACGTCGCAAGACCAAAGAGGGGGACCTTCGGGCCTCTTGCCATCGGATGTGCCCAGATGGGATTAGCTAGTAGGTGGGGTAACGGCTCACCTAGGCGACGATCCCTAGCTGGTCTGAGAGGATGACCAGCCACACTGGAACTGAGACACGGTCCAGACTCCTACGGGAGGCAGCAGTGGGGAATATTGCACAATGGGCGCAAGCCTGATGCAGCCATGCCGCGTGTATGAAGAAGGCCTTCGGGTTGTAAAGTACTTTCAGCGGGGAGGAAGGCGATAAGGTTAATAACCTTGTCGATTGACGTTACCCGCAGAAGAAGCACCGGCTAACTCCGTGCCAGCAGCCGCGGTAATACGGAGGGTGCAAGCGTTAATCGGAATTACTGGGCGTAAAGCGCACGCAGGCGGTCTGTCAAGTCGGATGTGAAATCCCCGGGCTCAACCTGGGAACTGCATTCGAAACTGGCAGGCTAGAGTCTTGTAGAGGGGGGTAGAATTCCAGGTGTAGCGGTGAAATGCGTAGAGATCTGGAGGAATACCGGTGGCGAAGGCGGCCCCCTGGACAAAGACTGACGCTCAGGTGCGAAAGCGTGGGGAGCAAACAGGATTAGATACCCTGGTAGTCCACGCCGTAAACGATGTCGACTTGGAGGTTGTGCCCTTGAGGCGTGGCTTCCGGAGCTAACGCGTTAAGTCGACCGCCTGGGGAGTACGGCCGCAAGGTTAAAACTCAAATGAATTGACGGGGGCCCGCACAAGCGGTGGAGCATGTGGTTTAATTCGATGCAACGCGAAGAACCTTACCTACTCTTGACATCCAGAGAACTTACCAGAGATGCATTGGTGCCTTCGGGAACTCTGAGACAGGTGCTGCATGGCTGTCGTCAGCTCGTGTTGTGAAATGTTGGGTTAAGTCCCGCAACGAGCGCAACCCTTATCCTTTGTTGCCAGCGGTTCGGCCGGGAACTCAAAGGAAACTGCCAGTGATAACTGGAGGAAGGTGGGGATGACGTCAGTCATCTGGCCCTTACAATAGGGCTACCACGTGCTACATGGCGCAA
- e.
- Isolate 5 (Enterobacter ludwigii)CTAACACATGCAAGTCGAACGGTAGCACAGAGAGCTTGCTCTCGGGTGACGAGTGGCGGACGGGTGAGTAATGTCTGGGAAACTGCCTGATGGAGGGGGATAACTACTGGAAACGGTAGCTAATACCGCATAACGTCGCAAGACCAAAGAGGGGGACCTTCGGGCCTCTTGCCATCAGATGTGCCCAGATGGGATTAGCTAGTAGGTGGGGTAACGGCTCACCTAGGCGACGATCCCTAGCTGGTCTGAGAGGATGACCAGCCACACTGGAACTGAGACACGGTCCAGACTCCTACGGGAGGCAGCAGTGGGGAATATTGCACAATGGGCGCAAGCCTGATGCAGCCATGCCGCGTGTATGAAGAAGGCCTTCGGGTTGTAAAGTACTTTCAGCGGGGAGGAAGGTGTTGTGGTTAATAACCGCAGCAATTGACGTTACCCGCAGAAGAAGCACCGGCTAACTCCGTGCCAGCAGCCGCGGTAATACGGAGGGTGCAAGCGTTAATCGGAATTACTGGGCGTAAAGCGCACGCAGGCGGTCTGTCAAGTCGGATGTGAAATCCCCGGGCTCAACCTGGGAACTGCATTCGAAACTGGCAGGCTAGAGTCTTGTAGAGGGGGGTAGAATTCCAGGTGTAGCGGTGAAATGCGTAGAGATCTGGAGGAATACCGGTGGCGAAGGCGGCCCCCTGGACAAAGACTGACGCTCAGGTGCGAAAGCGTGGGGAGCAAACAGGATTAGATACCCTGGTAGTCCACGCCGTAAACGATGTCGACTTGGAGGTTGTGCCCTTGAGGCGTGGCTTCCGGAGCTAACGCGTTAAGTCGACCGCCTGGGGAGTACGGCCGCAAGGTTAAAACTCAAATGAATTGACGGGGGCCCGCACAAGCGGTGGAGCATGTGGTTTAATTCGATGCAACGCGAAGAACCTTACCTACTCTTGACATCCAGAGAACTTTCCAGAGATGGATTGGTGCCTTCGGGAACTCTGAGACAGGTGCTGCATGGCTGTCGTCAGCTCGTGTTGTGAAATGTTGGGTTAAGTCCCGCAACGAGCGCAACCCTTATCCTTTGTTGCCAGCGGTCCGGCCGGGAACTCAAAGGAGACTGCCAGTGATAACTGGAGGAAGGTGGGGATGACGTCAGTCATCATGGCCCTTACGAGTAGGGCTACACACGTGCTACATGG
- f.
- Isolate 6 (Staphylococcus aureus)CGCATGCTAATACATGCAAGTCGAGCGAACGGACGAGAAGCTTGCTTCTCTGATGTTAGCGGCGGACGGGTGAGTAACACGTGGATAACCTACCTATAAGACTGGGATAACTTCGGGAAACCGGAGCTAATACCGGATAATATTTTGAACCGCATGGTTCAAAAGTGAAAGACGGTCTTGCTGTCACTTATAGATGGATCCGCGCTGCATTAGCTAGTTGGTAAGGTAACGGCTTACCAAGGCAACGATGCATAGCCGACCTGAGAGGGTGATCGGCCACACTGGAACTGAGACACGGTCCAGACTCCTACGGGAGGCAGCAGTAGGGAATCTTCCGCAATGGGCGAAAGCCTGACGGAGCAACGCCGCGTGAGTGATGAAGGTCTTCGGATCGTAAAACTCTGTTATTAGGGAAGAACATATGTGTAAGTAACTGTGCACATCTTGACGGTACCTAATCAGAAAGCCACGGCTAACTACGTGCCAGCAGCCGCGGTAATACGTAGGTGGCAAGCGTTATCCGGAATTATTGGGCGTAAAGCGCGCGTAGGCGGTTTTTTAAGTCTGATGTGAAAGCCCACGGCTCAACCGTGGAGGGTCATTGGAAACTGGAAAACTTGAGTGCAGAAGAGGAAAGTGGAATTCCATGTGTAGCGGTGAAATGCGCAGAGATATGGAGGAACACCAGTGGCGAAGGCGACTTTCTGGTCTGTAACTGACGCTGATGTGCGAAAGCGTGGGGATCAAACAGGATTAGATACCCTGGTAGTCCACGCCGTAAACGATGAGTGCTAAGTGTTAGGGGGTTTCCGCCCCTTAGTGCTGCAGCTAACGCATTAAGCACTCCGCCTGGGGAGTACGACCGCAAGGTTGAAACTCAAAGGAATTGACGGGGACCCGCACAAGCGGTGGAGCATGTGGTTTAATTCGAAGCAACGCGAAGAACCTTACCAAATCTTGACATCCTTTGACAACTCTAGAGATAGAGCCTTCCCCTTCGGGGGACAAAGTGACAGGTGGTGCATGGTTGTCGTCAGCTCGTGTCGTGAGATGTTGGGTTAAGTCCCGCAACGAGCGCAACCCTTAAGCTTAGTTGCCATCATTAAGTTGGGCACTCTAAGTTGACTGCCGGTGACAAACCGGAAGAAAGGTGGGGATGACGTCAAATCATCATGCCCCTTATGATTTGGGCTACCC
2.3.4. Antibiotic Susceptibility Test
2.3.5. Antibacterial Activity of Methanolic Extract of Haloxylon scoparium
3. Discussion
4. Materials and Methods
4.1. Plant Material Collection
4.2. Extracts Preparation
4.3. HPLC-DAD of the Phenolic Profile of Methanol Extract
4.4. Acute Oral Toxicity Study in Mice
4.5. Antibacterial Assays of H. scoparium Extracts
4.5.1. Collection of Urine Samples
4.5.2. Isolation of Bacterial Species
4.5.3. Biochemical Investigation
4.5.4. Antibiotic Susceptibility Tests
4.5.5. DNA Isolation and PCR Amplification
4.5.6. Sequencing of 16S rRNA and Phylogenetic Analysis
4.5.7. Agar Well Diffusion Assay
4.5.8. TTC Colorimetric Assay for the Evaluation of Minimum Inhibitory Concentration (MIC) and Minimum Bactericidal Concentration (MBC)
4.6. Data Analysis
- H0: The means are equal across all concentrations.
- H1: At least one concentration has a significantly different mean.
- Normality: The residuals appeared approximately normally distributed based on visual inspection.
- Homogeneity of variances: Variance across groups was roughly similar, satisfying the homoscedasticity assumption.
5. Conclusions
Author Contributions
Funding
Institutional Review Board Statement
Informed Consent Statement
Data Availability Statement
Conflicts of Interest
References
- WHO: World Health Organisation. Urinary Tract Infection; WHO: Geneva, Switzerland, 2011. [Google Scholar]
- Gupta, P.; Gupta, K. The profile of uropathogens and their antibiotic susceptibility in IPD adults in a tertiary care hospital in North India. Int. J. Curr. Microbiol. App. Sci. 2018, 7, 3190–3197. [Google Scholar] [CrossRef]
- Raka, L.; Spahija, G.; Gashi-Gecaj, A.; Hamza, A.; Haxhiu, E.; Rashiti, A.; Rrahimi, G.; Hyseni, S.; Petrosillo, N. Point prevalence survey of healthcare-associated infections and antimicrobial use in Kosovo hospitals. Infect. Dis. Rep. 2019, 11, 4–10. [Google Scholar] [CrossRef]
- Cohen, M.L. Epidemiology of drug resistance: Implications for a post--antimicrobial era. Science 1992, 257, 1050–1055. [Google Scholar] [CrossRef]
- WHO: World Health Organisation. Global Priority List of Antibiotic-Resistance Bacteria to Guide Research, Discovery, and Development of New Antibiotics; WHO: Geneva, Switzerland, 2017. [Google Scholar]
- Gulen, T.A.; Guner, R.; Celikbilek, N.; Keske, S.; Tasyaran, M. Clinical importance and cost of bacteremia caused by nosocomial multi drug resistant Acinetobacter baumannii. Int. J. Infect. Dis. 2015, 38, 32–35. [Google Scholar] [CrossRef]
- WHO: Word Health Organisation. New Report Calls for Urgent Action to Avert Antimicrobial Resistance Crisis; WHO: Geneva, Switzerland, 2019. [Google Scholar]
- Tadesse, B.T.; Ashley, E.A.; Ongarello, S.; Havumaki, J.; Wijegoonewardena, M.; González, I.; Dittrich, S. Antimicrobial resistance in Africa: A systematic review. BMC Infect. Dis. 2017, 17, 616. [Google Scholar] [CrossRef]
- Subramani, R.; Narayanaswamy, M.; Feussner, K.D. Plant-derived antimicrobials to fight against multi-drug-resistant human pathogens. 3 BioTech 2017, 7, 172. [Google Scholar] [CrossRef]
- Kessler, A.; Kalske, A. Plant secondary metabolite diversity and species interactions. Annu. Rev. Ecol. Evol. Syst. 2018, 49, 115–138. [Google Scholar] [CrossRef]
- Gupta, P.D.; Daswani, P.; Birdi, T.J. Approaches in fostering quality parameters for medicinal botanicals in the Indian context. Indian J. Pharmacol. 2014, 46, 363–371. [Google Scholar] [CrossRef]
- Sakarikou, C.; Kostoglou, D. Manuel Simões, Efstathios Giaouris, Exploitation of plant extracts and phytochemicals against resistant Salmonella spp. in biofilms. Food Res. Int. 2020, 128, 108806. [Google Scholar] [CrossRef]
- Ziani, B.E.C.; Barros, L.; Boumehira, A.Z.; Bachari, K.; Heleno, S.A.; Alves, M.J.; Ferreira, I.C.F.R. Profiling polyphenol composition by HPLC-DAD-ESI/MSn and the antibacterial activity of infusion preparations obtained from four medicinal plants. Food Funct. 2018, 9, 149–159. [Google Scholar] [CrossRef]
- Gelin, Z.; Mosyakin, S.L.; Clemants, S.E. Chenopodiaceae. Flora China 2003, 5, 351–414. [Google Scholar]
- Täckholm, V. Students’ Flora of Egypt, 2nd ed.; Cairo University Publishing: Beirut, Lebanon, 1974; p. 888. [Google Scholar]
- Boulos, L. Flora of Egypt, Vol. 1, 2, 4; Al-Hadara Publishing: Cairo, Egypt, 1999. [Google Scholar]
- Ezzeddine, B.; Raoudha, J.M.; Lokesh, D.; Abdelfattah, E.F. Therapeutic Efficacy of Hammada scoparia Extract Against Ethanol Induced Renal Dysfunction in Wistar Rats. J. Food Biochem. 2016, 41, e12307. [Google Scholar] [CrossRef]
- Bellakhdar, J. La pharmacopée marocaine traditionnelle. In Médecine Arabe Ancienne Et Savoirs Populaires, Paris; Ibis Press: Paris, France, 2023; p. 766. [Google Scholar]
- Ben Salah, H.; Jarraya, R.; Martin, M.T.; Veitch, N.C.; Grayer, R.J.; Simmonds, M.S.; Damak, M. Flavonol triglycosides from the leaves of Hammada scoparia (POMEL) ILJIN. Chem. Pharm. Bull. 2000, 50, 1268–1270. [Google Scholar] [CrossRef]
- Lamchouri, F.; Benali, T.; Bennani, B.; Toufik, H.; Hassani, L.; Bouachrine, M. Preliminary phytochemical and antimicrobial investigations of extracts of Haloxylon scoparium. J. Mater. Environ. Sci. 2012, 3, 754–759. [Google Scholar]
- Benine, C.; Djahra, A.B.; Ammar, T.A.L.; Rebiai, A. A systematic review on Hammada scoparia medicinal plant: Phytochemicals, traditional uses and biological activities. Int. J. Second. Metab. 2023, 10, 137–146. [Google Scholar] [CrossRef]
- Aiyegoro, O.A.; Igbinosa, O.O.; Ogunmwonyi, I.N.; Odjadjare, E.E.; Igbinosa, O.E.; Okoh, A.I. Incidence of urinary tract infections (UTI) among children and adolescents in lle-lfe, Niger. Afr. J. Microbiol. Res. 2007, 1, 13–19. [Google Scholar]
- Wu, Q.; Li, Y.; Wang, M.; Pan, X.P.; Tang, Y.F. Fluorescence in situ hybridization rapidly detects three different pathogenic bacteria in urinary tract infection samples. J. Microbiol. Meth. 2010, 83, 175–178. [Google Scholar] [CrossRef]
- Said, A.; El-Gamal, M.S.; Abu-Elghait, M.; Salem, S.S. Isolation, identification and antibiotic susceptibility pattern of urinary tract infection bacterial isolates. Lett Appl. NanoBioSci. 2021, 10, 2820–2830. [Google Scholar]
- CLSI. Performance Standards for Antimicrobial Disk and Dilution Susceptibility Tests, 6th ed.; Wayne: CLSI Supplement VET01S; Clinical and Laboratory Standards Institute: Nashville, TN, USA, 2023. [Google Scholar]
- Jarraya, R.; Ben-Salah, H.; Damak, M. Chemical and radical scavenging activity of constituents from Hammada scoparia (pomel) IIjin. J. Société Chim. Tunis. 2005, 7, 261–266. [Google Scholar]
- Chao, H.C.; Najjaa, H.; Villareal, M.O.; Ksouri, R.; Han, J.; Neffati, M.; Isoda, H. Arthrophytum scoparium Inhibits Melanogenesis Through the Down-Regulation of Tyrosinase and Melanogenic Gene Expressions in b16 Melanoma Cells. Exp. Derm. 2013, 22, 131–136. [Google Scholar] [CrossRef]
- Benkherara, S.; Bordjıba, O.; Harrat, S.; Djahra, A.B. Antidiabetic Potential and Chemical Constituents of Haloxylon scoparium Aerial Part, An Endemic Plant from Southeastern Algeria. Int. J. Second. Metab. 2021, 8, 398–413. [Google Scholar] [CrossRef]
- Otmani, R.; Khene, B.; Kemassi, A.; Araba, F.; Harrat, M.; Yousfi, M. Phytochemical profile and allelopathic potential of Haloxylon scoparium Pomel (Chenopodiaceae) from Algerian Sahara. Acta Agric. Slov. 2023, 119, 1–11. [Google Scholar] [CrossRef]
- Leouifoudi, I.; Harnafi, H.; Zyad, A. Olive mill waste Extracts: Polyphenols content, antioxidant, and antimicrobial activities. Adv. Pharmacol. Sci. 2015, 2015, 714138. [Google Scholar] [CrossRef] [PubMed]
- Bourgou, S.; Bettaieb, R.I.; Mkadmini, K.; Isoda, H.; Ksouri, R.; Ksouri, W.M. LC-ESI-TOF-MS and GC-MS profiling of Artemisia herba-alba and evaluation of its bioactive properties. Food Res. Int. 2017, 99, 702–712. [Google Scholar] [CrossRef]
- Borges, A.; Ferreira, C.; Saavedra, M.J.; Simões, M. Antibacterial activity and mode of action of ferulic and gallic acids against pathogenic bacteria. Microb. Drug Resist. 2013, 19, 256–265. [Google Scholar] [CrossRef]
- Almeida, A.; Farah, A.; Silva, D.; Nunan, E.; Gloria, M. Antibacterial activity of coffee extracts and selected coffee chemical compounds against enterobacteria. J. Agric. Food Chem. 2006, 54, 8738–8743. [Google Scholar] [CrossRef]
- Lou, Z.; Wang, H.; Zhu, S.; Ma, C.; Wang, Z. Antibacterial activity and mechanism of action of chlorogenic acid. J. Food Sci 2011, 76, 398–403. [Google Scholar] [CrossRef]
- Sung, W.S.; Lee, D.G. Antifungal action of chlorogenic acid against pathogenic fungi, mediated by membrane disruption. Pure Appl. Chem. 2010, 82, 219–226. [Google Scholar] [CrossRef]
- Wu, M.; Brown, A.C. Applications of Catechins in the Treatment of Bacterial Infections. Pathogens 2021, 10, 546. [Google Scholar] [CrossRef]
- Kozyra, M.; Biernasiuk, A.; Malm, A. Analysis of phenolic acids and antibacterial activity of extracts obtained from the flowering herbs of Carduus acanthoides L. Acta Pol. Pharm. 2017, 74, 161–172. [Google Scholar] [PubMed]
- Teffo, L.S.; Aderogba, M.A.; Eloff, J.N. Antibacterial and antioxidant activities of four kaempferol methyl ethers isolated from Dodonaea viscosa Jacq. var. angustifolia leaf extracts. S. Afr. J. Bot. 2010, 76, 25–29. [Google Scholar] [CrossRef]
- Cushnie, T.P.T.; Lamb, A.J. Recent Advances in Understanding the Antibacterial Properties of Flavonoids. Int. J. Antimicrob. Agents 2011, 38, 99–107. [Google Scholar] [CrossRef] [PubMed]
- Wink, M. Modes of Action of Herbal Medicines and Plant Secondary Metabolites. Medicines 2015, 2, 251–286. [Google Scholar] [CrossRef] [PubMed]
- Burt, S. Essential oils: Their antibacterial properties and potential applications in foods—A review. Int. J. Food Microbiol. 2004, 94, 223–253. [Google Scholar] [CrossRef]
- Borugă, O.; Jianu, C.; Mişcă, C.; Goleţ, I.; Gruia, A.T.; Horhat, F.G. Thymus vulgaris essential oil: Chemical composition and antimicrobial activity. J. Med. Life 2014, 7, 56–60. [Google Scholar] [PubMed]
- Lachkar, N.; Lamchouri, F.; Bouabid, K.; Senhaji, S.; Boulfia, M.; Akabli, T.; Zalaghi, A.; Toufik, H. In vitro study of the antimitotic power and in vivo acute toxicity of aqueous and organic extracts of the aerial part of Haloxylon scoparium Pomel. and evaluation of the correlation between the chemical profile and their biological activities. Plant Sci. 2023, 10, 242–251. [Google Scholar] [CrossRef]
- Kharchoufa, L.; Bouhrim, M.; Bencheikh, N.; El Assri, S.; Amirou, A.; Yamani, A.; Choukri, M.; Mekhfi, H.; Elachouri, M. Acute and Subacute Toxicity Studies of the Aqueous Extract from Haloxylon scoparium Pomel (Hammada scoparia (Pomel)) by Oral Administration in Rodents. BioMed Res. Int. 2020, 2020, 4020647. [Google Scholar] [CrossRef]
- Kumar, M.S.; Ghosh, S.; Nayak, S.; Das, A.P. Recent advances in biosensor based diagnosis of urinary tract infection. Biosens. Bioelectron. 2016, 80, 497–510. [Google Scholar] [CrossRef]
- Jackson, N.; Borges, C.A.; Tarlton, N.J.; Resendez, A.; Milton, A.K.; de Boer, T.R.; Butcher, C.R.; Murthy, N.; Riley, L.W. A rapid, antibiotic susceptibility test for multidrug-resistant, Gram-negative bacterial uropathogens using the biochemical assay, DETECT. J. Microbio. Methods 2021, 182, 106160. [Google Scholar] [CrossRef]
- Alhomayani, F.K.; Alazwari, N.M.; Alshhrani, M.S.; Alkhudaydi, A.S.; Basaba, A.S.; Alharthi, T.M.; Alghamdi, M.M.; Aljuaid, A.S.; Alosimi, N.M.; Alqethami, A.M. The prevalence of multiple drug resistant urinary tract infections: A single-centered, observational retrospective study in King Abdulaziz Specialized Hospital, Taif, Saudi Arabia. Saudi Med J. 2022, 43, 927–932. [Google Scholar] [CrossRef]
- Khan, A.; Saraf, V.S.; Siddiqui, F.; Batool, T.; Noreen, Z.; Javed, S.; Ahmad, A.; Alonazi, W.B.; Ibrahim, M.; Pucciarelli, S.; et al. Multidrug resistance among uropathogenic clonal group A E. Coli isolates from Pakistani women with uncomplicated urinary tract infections. BMC Microbiol. 2024, 24, 74. [Google Scholar] [CrossRef] [PubMed]
- Pallett, A.; Hand, K. Complicated urinary tract infections: Practical solutions for the treatment of multiresistant Gram-negative bacteria. J. Antimicrob. Chemother. 2010, 65, 25–33. [Google Scholar] [CrossRef] [PubMed]
- Uddin, T.M.; Chakraborty, A.J.; Khusro, A.; Zidan, R.M.; Mitra, S.; Emran, T.B.; Dhama, K.; Ripon, K.H.; Gajdács, M.; Sahibzada, M.U.K.; et al. Antibiotic resistance in microbes: History, mechanisms, therapeutic strategies and future prospects. J. Infect. Public Health 2021, 14, 1750–1766. [Google Scholar] [CrossRef] [PubMed]
- Regassa, B.T.; Tosisa, W.; Eshetu, D.; Beyene, D.; Abdeta, A.; Negeri, A.A.; Teklu, D.S.; Tasew, G.; Tulu, B.; Awoke, T. Antimicrobial resistance profiles of bacterial isolates from clinical specimens referred to Ethiopian Public Health Institute: Analysis of 5-year data. BMC Infect. Dis. 2023, 23, 40. [Google Scholar] [CrossRef]
- Bobate, S.; Mahalle, S.; Dafale, N.A.; Bajaj, A. Emergence of environmental antibiotic resistance: Mechanism, monitoring and management. Environ. Adv. 2023, 13, 100409. [Google Scholar] [CrossRef]
- Tarek, A.; Abdalla, S.; Dokmak, N.A.; Ahmed, A.A.; El-Mahdy, T.S.; Safwat, N.A. Bacterial Diversity and Antibiotic Resistance Patterns of Community-Acquired Urinary Tract Infections in Mega Size Clinical Samples of Egyptian Patients: A Cross-Sectional Study. Cureus 2024, 16, 51838. [Google Scholar] [CrossRef]
- Mancuso, G.; Midiri, A.; Gerace, E.; Biondo, C. Bacterial Antibiotic Resistance: The Most Critical Pathogens. Pathogens 2021, 10, 1310. [Google Scholar] [CrossRef]
- Urban-Chmiel, R.; Marek, A.; Stępień-Pyśniak, D.; Wieczorek, K.; Dec, M.; Nowaczek, A.; Osek, J. Antibiotic Resistance in Bacteria-A Review. Antibiotics 2022, 11, 1079. [Google Scholar] [CrossRef]
- Miller, S.I. Antibiotic Resistance and Regulation of the Gram-Negative Bacterial Outer Membrane Barrier by Host Innate Immune Molecules. mBio 2016, 7, 5. [Google Scholar] [CrossRef]
- Exner, M.; Bhattacharya, S.; Christiansen, B.; Gebel, J.; Goroncy-Bermes, P.; Hartemann, P.; Heeg, P.; Ilschner, C.; Kramer, A.; Larson, E.; et al. Antibiotic resistance: What is so special about multidrug-resistant Gram-negative bacteria? GMS Hyg. Infect. Control. 2017, 12, 12. [Google Scholar] [CrossRef]
- Datta, P.; Gupta, V. Next-generation strategy for treating drug resistant bacteria: Antibiotic hybrids. Indian J. Med. Res. 2019, 149, 97–106. [Google Scholar] [CrossRef]
- Kaushik, S.; Tomar, R.; Tiwari, U.; Saraswat, A.; Shrivastav, A. Antimicrobial investigation of different medications against nosocomial infections causing staphylococcus aureus. Inter J. Dev. Res. 2014, 4, 1–3. [Google Scholar]
- Sirwan, K.A.; Safin, H.; Karzan, Q.; Radhwan, H.I.; Abdulmalik, F.; Kochr, A.M.; Mona, G.M. Antimicrobial resistance: Impacts, challenges, and future prospects. J. Med. Surg. Public Health 2024, 2, 81. [Google Scholar] [CrossRef]
- Devi, N.S.; Mythili, R.; Cherian, T.; Dineshkumar, R.; Sivaraman, G.K.; Jayakumar, R.; Prathaban, M.; Duraimurugan, M.; Chandrasekar, V.; Peijnenburg, W.J.G.M. Overview of antimicrobial resistance and mechanisms: The relative status of the past and current. Microbe 2024, 3, 100083. [Google Scholar] [CrossRef]
- Olesen, S.W.; Barnett, M.L.; MacFadden, D.R.; Brownstein, J.S.; Hernández-Díaz, S.; Lipsitch, M.; Grad, Y.H. The distribution of antibiotic use and its association with antibiotic resistance. Elife 2018, 7, e39435. [Google Scholar] [CrossRef]
- Fwoloshi, S.; Chola, U.; Nakazwe, R.; Tatila, T.; Mateele, T.; Kabaso, M.; Muzyamba, T.; Mutwale, I.; St Clair Jones, A.; Islam, J.; et al. Why local antibiotic resistance data matters–Informing empiric prescribing through local data collation, app design and engagement in Zambia. J. Infect. Public Health 2023, 16, 69–77. [Google Scholar] [CrossRef]
- Muteeb, G.; Rehman, M.T.; Shahwan, M.; Aatif, M. Origin of Antibiotics and Antibiotic Resistance, and Their Impacts on Drug Development: A Narrative Review. Pharmaceuticals 2023, 16, 1615. [Google Scholar] [CrossRef]
- Murray, C.J.L. Antimicrobial Resistance Collaborators. Global burden of bacterial antimicrobial resistance in 2019: A systematic analysis. Lancet 2022, 399, 629–655. [Google Scholar] [CrossRef]
- Cushnie, T.P.; Lamb, A.J. Antimicrobial activity of flavonoids. Int. J. Antimicrob. Agents 2005, 26, 343–356. [Google Scholar] [CrossRef]
- Wu, T.; Zang, X.; He, M.; Pan, S.; Xu, X. Structure–Activity Relationship of Flavonoids on Their Anti-Escherichia coli Activity and Inhibition of DNA Gyrase. J. Agric. Food Chem. 2013, 61, 8185–8190. [Google Scholar] [CrossRef]
- Xie, Y.; Yang, W.; Tang, F.; Chen, X.; Ren, L. Antibacterial Activities of Flavonoids: Structure-Activity Relationship and Mechanism. Curr. Med. Chem. 2014, 22, 132–149. [Google Scholar] [CrossRef] [PubMed]
- Górniak, I.; Bartoszewski, R.; Króliczewski, J. Comprehensive review of antimicrobial activities of plant flavonoids. Phytochem. Rev. 2019, 18, 241–272. [Google Scholar] [CrossRef]
- Biharee, A.; Sharma, A.; Kumar, A.; Jaitak, V. Fitoterapia Antimicrobial flavonoids as a potential substitute for overcoming antimicrobial resistance. Fitoterapia 2020, 146, 104720. [Google Scholar] [CrossRef] [PubMed]
- Donadio, G.; Mensitieri, F.; Santoro, V.; Parisi, V.; Bellone, M.; De Tommasi, N.; Izzo, V.; Piaz, F.D. Interactions with Microbial Proteins Driving the Antibacterial Activity of Flavonoids. Pharmaceutics 2021, 13, 660. [Google Scholar] [CrossRef]
- Shamsudin, N.F.; Ahmed, Q.U.; Mahmood, S.; Ali Shah, S.A.; Khatib, A.; Mukhtar, S.; Alsharif, M.A.; Parveen, H.; Zakaria, Z.A. Antibacterial Effects of Flavonoids and Their Structure-Activity Relationship Study: A Comparative Interpretation. Molecules 2022, 27, 1149. [Google Scholar] [CrossRef]
- Yan, Y.; Xia, X.; Fatima, A.; Zhang, L.; Yuan, G.; Lian, F.; Wang, Y. Antibacterial Activity and Mechanisms of Plant Flavonoids against Gram-Negative Bacteria Based on the Antibacterial Statistical Model. Pharmaceuticals 2024, 17, 292. [Google Scholar] [CrossRef]
- Schmidt, T.J.; Khalid, S.A.; Romanha, A.J.; Alves, T.M.A.; Biavatti, M.W.; Brun, R.; Da Costa, F.B.; De Castro, S.L.; Ferreira, V.F.; De Lacerda, M.V.G.; et al. The potential of secondary metabolites from plants as drugs or leads against protozoan neglected diseases-part II. Curr. Med. Chem. 2012, 19, 2176–2228. [Google Scholar] [CrossRef]
- Daglia, M. Polyphenols as antimicrobial agents. Curr. Opin. Biotechnol 2012, 23, 174–181. [Google Scholar] [CrossRef]
- Li, A.N.; Li, S.; Zhang, Y.J.; Xu, X.R.; Chen, Y.M.; Li, H.B. Resources and biological activities of natural polyphenols. Nutrients 2014, 6, 6020–6047. [Google Scholar] [CrossRef]
- Liu, J.; Du, C.; Beaman, H.T.; Monroe, M.B.B. Characterization of Phenolic Acid Antimicrobial and Antioxidant Structure-Property Relationships. Pharmaceutics 2020, 12, 419. [Google Scholar] [CrossRef]
- Lobiuc, A.; Pavăl, N.E.; Mangalagiu, I.I.; Gheorghiță, R.; Teliban, G.C.; Amăriucăi-Mantu, D.; Stoleru, V. Future Antimicrobials: Natural and Functionalized Phenolics. Molecules 2023, 28, 1114. [Google Scholar] [CrossRef] [PubMed]
- Arsene, M.M.J.; Viktorovna, P.I.; Davares, A.K.L. Galleria mellonella (greater wax moth) as an eco-friendly in vivo approach for the assessment of the acute toxicity of medicinal plants: Application to some plants from Cameroon. Open Vet J. 2021, 11, 651–661. [Google Scholar] [CrossRef] [PubMed]
- Caponio, F.; Alloggio, V.; Gomes, T. Phenolic Compounds of Virgin Olive Oil; Influence of Paste Preparation Techniques. Food Chemistry 1999, 64, 203–209. [Google Scholar] [CrossRef]
- Saleem, U.; Amin, S.; Ahmad, B.; Azeem, H.; Anwar, F.; Mary, S. Acute oral toxicity evaluation of aqueous ethanolic extract of Saccharum munja Roxb. roots in albino mice as per OECD 425 TG. Toxicol. Rep. 2017, 4, 580–585. [Google Scholar] [CrossRef]
- Pobiega, M.; Maciag, J.; Wesolowska, M.P.; Chmielarczyk, A.; Romaniszyn, D.; Ziolkowski, G.; Heczko, P.B.; Mach, J.W.; Bulanda, M. Urinary tract infections caused by Pseudomonas aeruginosa among children in Southern Poland: Virulence factors and antibiotic resistance. J. Pediatr. Urol. 2015, 12, 36e. [Google Scholar] [CrossRef]
- Sachu, A.; Samuel, A.K. Evaluation of chromogenic agar medium, can it be a suitable alternative to conventional culture system for identification of uropathogens? Iran. J. Microbiol. 2022, 14, 825–831. [Google Scholar] [CrossRef]
- Shoebitz, M.; Ribaudo, C.M.; Pardo, M.A.; Cantore, M.L.; Ciampi, L.; Curá, J.A. Plant growth promoting properties of a strain of Enterobacter ludwigii isolated from Lolium perenne rhizosphere. Soil Biol. Biochem. 2009, 41, 1768–1774. [Google Scholar] [CrossRef]
- Brown, V.I.; Lowbury, E.J.L. Use of an improved cetrimide agar medium and other culture methods for Pseudomonas aeruginosa. J. Clin. Pathol. 1965, 18, 752–756. [Google Scholar] [CrossRef]
- Chang, C.W.; Wang, L.J. Impact of culture media and sampling methods on Staphylococcus aureus aerosols. Indoor Air 2015, 25, 488–498. [Google Scholar] [CrossRef]
- Beyene, G.; Tsegaye, W. Bacterial Uropathogens in Urinary Tract Infection and Antibiotic Suseptibility Pattern in Jimma University Specialized Hospital, South West Ethiopia. Ethiopian J. Health Sci. 2011, 21, 141–146. [Google Scholar] [CrossRef]
- CA-SFM (Comité de l’antibiogramme de la Société Française de Microbiologie). Recommandations 2024, 1.0 Juin; Société Française de Microbiologie, Ed.; CA-SFM: Paris, France, 2024; pp. 1–177. [Google Scholar]
- Cappuccino, J.G.; Sherman, N. Microbiology A Laboratory Manual, 5th ed.; The Benjamin/Cummings Publishing Company Inc.: San Francisco, CA, USA, 1999; p. 129. [Google Scholar]
- Wang, M.; Wei, H.; Zhao, Y.; Shang, L.; Di, L.; Lyu, C.; Liu, J. Analysis of multidrug-resistant bacteria in 3223 patients with hospital-acquired infections (HAI) from a tertiary general hospital in China. Bosn. J Basic Med Sci 2019, 19, 86–93. [Google Scholar] [CrossRef] [PubMed]
- Perez, C.; Pauli, M.; Bazerque, P. An Antibiotic Assay by Agar Well Diffusion Method. Acta Biol. Med. Experi. 1990, 15, 113–115. [Google Scholar]
- Ahmad, I.; Beg, A.Z. Antimicrobial and Phytochemical Studies on 45 Indian Medicinal Plants against Multi-Drug and Resistant Human Pathogens. J. Ethnopharmacol. 2001, 74, 113–123. [Google Scholar] [CrossRef] [PubMed]
- Aref, H.L.; Bel Hadj, S.K.; Fekih, A.; Chemli, R.; Mars, M.; Aouni, M.; Chaumon, J.P.; Said, K. Variability in antimicrobial activity of latex from two varieties of Ficus carica. Afri. J. Microb. Res. 2011, 5, 1361–1367. [Google Scholar]

| Peak No | Compound | Compound Families | Compound Subfamilies | Retention Time [min] | Concentration [mg/g Extract] | Abs λ [nm] |
|---|---|---|---|---|---|---|
| 1 | Ascorbic acid | Vitamins | 4.771 | 0.0124 | 254 | |
| 2 | Gallic acid | Phenolic acids | Hydroxybenzoic acid | 7.316 | 0.032 | 280 |
| 3 | Protocatchuic acid | 10.44 | 0.052 | 280 | ||
| 4 | Chlorogenic acids | Hydroxycinnamic acid | 11.44 | 1.928 | 280 | |
| 5 | Catechin | Flavonoids | Flavan-3-ol | 12.16 | 3.208 | 254 |
| 6 | Unknown | - | - | 12.75 | 3.924 | 254 |
| 7 | Caffeic acid | Phenolic | Hydroxycinnamic acid | 13.505 | 1.392 | 280 |
| 8 | Epicatechin | Flavonoid | Flavan-3-ol | 13.521 | 47.516 | 254 |
| 9 | Vanillic acid | Phenolic acids | Hydroxybenzoic acid | 14.16 | 0.068 | 254 |
| 10 | Rutin | Flavonoid | Flavonol glycoside | 15.35 | 1.472 | 254 |
| 11 | Luteolin glucoside | Flavonoid | Flavone glycosides | 16.323 | 1.54 | 330 |
| 12 | p-coumaric acid | Phenolic acids | Hydroxycinnamic acid derivative | 17.138 | 0.724 | 330 |
| 13 | Apigenin-7-glucoside | Flavonoid | Flavone glycosides | 18.136 | 1.272 | 330 |
| 14 | Ferulic acid | Phenolic acids | Hydroxycinnamic Acid derivative | 18.339 | 0.184 | 280 |
| 15 | Naringinin | Flavonoid | Flavanone | 20.901 | 0.368 | 280 |
| 16 | Luteolin | Flavonoid | Flavone | 22.926 | 0.096 | 330 |
| 17 | Quercetin | Phenolic | Flavonol | 23.048 | 0.252 | 254 |
| 18 | Apigenine | Flavonoid | Flavone | 25.704 | 0.216 | 280 |
| Sum of all compounds | 64.536 | |||||
| Sum of flavonoids | 55.77 | |||||
| Sum of phenolic acids | 8.766 | |||||
| Biochemical Test | UTI-1 | UTI-2 | UTI-3 | UTI-4 | UTI-5 | UTI-6 |
|---|---|---|---|---|---|---|
| Gram staining | - | - | - | - | - | + |
| Motility | Non-motile | Motile | Motile | Motile | Motile | Non-motile |
| Oxidase | - | - | - | - | + | - |
| Catalase | + | + | + | + | + | + |
| Nitrate | + | + | + | + | + | + |
| Methyl red | + | + | + | + | - | + |
| Voges–Proskaeur | + | - | + | + | - | + |
| Citrate | + | - | + | + | + | + |
| Indole | - | + | - | - | - | - |
| Starch hydrolysis | - | - | + | + | - | + |
| Description | Scientific Name | Max Score | Totale Score | Query Cover | E Value | Per. Ident | Acc. Len | Accession |
|---|---|---|---|---|---|---|---|---|
| Klebsiella pneumoniae strain KT 3 16S ribosomal RNA gene, partial sequence | Klebsiella pneumoniae | 2167 | 2167 | 100% | 0.0 | 99.33% | 1416 | MT740433.1 |
| Escherichia coli strain AF1 16S ribosomal RNA gene, partial sequence | Escherichia coli | 1626 | 1626 | 99% | 0.0 | 98.28% | 1190 | ON653022.1 |
| Pseudomonas aeruginosa strain NBFPALD_RAS140 16S ribosomal RNA gene, partial sequence | Pseudomonas aeruginosa | 2209 | 2209 | 100% | 0.0 | 99.43% | 1455 | KJ819583.1 |
| Enterobacter hormaechei subsp. xiangfangensis strain UWIBGS3 16S ribosomal RNA gene, partial sequence | Enterobacter hormaechei subsp. xiangfangensis | 2115 | 2115 | 100% | 0.0 | 99.23% | 1491 | MG923793.1 |
| Enterobacter ludwigii strain AFS065241 16S ribosomal RNA gene, partial sequence | Enterobacter ludwigii | 2183 | 2183 | 100% | 0.0 | 99.75% | 1527 | OP986255.1 |
| Staphylococcus aureus strain 8QC4O2 16S ribosomal RNA gene, partial sequence | Staphylococcus aureus | 2200 | 2200 | 99% | 0.0 | 100% | 1451 | OP068064.1 |
| Clinical MDR Isolate | Antibiotic Resistance Patterns |
|---|---|
| K. pneumoniae | AMP, AMC, CZN, FOX, CTX, ETP, AMK, GMN, NAL, TET, SXT |
| E. coli | AMP, AMC, FOX, CTX, ETP, GMN, NAL, SXT |
| P. aeruginosa | PI, LVX, CIP, GMN, TOB, IMP |
| E. hormaechei | AMP, AMC, CZN, CTX, GMN, SXT |
| E. ludwigii | FOX, LVX, CIP, OFX, KAN, GMN, AMK, CMN, ERY, TET, QDA |
| S. aureus | FOX, KAN, GMN, AMK, CMN, ERY, TET, QDA |
| The Diameter of Inhibition Zones (mm) (mean ± SD) | |||||||
|---|---|---|---|---|---|---|---|
| MDR Bacteria | Methanolic Extract (µg/mL) | Positive Control | Negative Control | ||||
| 50 | 100 | 150 | 200 | ETP (10 μg) | RP (10 μg) | DMSO (10%) | |
| K. pneumoniae | 8.0 ± 0.80 | 9.0 ± 0.71 | 11.0 ± 0.4 | 14.75 ± 0.35 | 14.5 ± 1.2 | - | 0 |
| E. hormaechei | 7.0 ± 0.00 | 7.37 ± 0.13 | 9.5 ± 0.17 | 11.0 ± 0.35 | 30.50 ± 0.2 | - | 0 |
| E. ludwigii | 8.75 ± 0.0 | 11.5 ± 0.5 | 14.5 ± 0.5 | 16.0 ± 0.5 | - | 22.50 ± 0.8 | 0 |
| E. coli | 0 | 8.0 ±1.41 | 14.0 ±0.23 | 17.25 ± 0.35 | 10.0± 0.8 | - | 0 |
| P. aeruginosa | 0 | 7.5 ± 0.71 | 8.5 ± 0.43 | 9.25 ± 0.32 | 30.50 ± 0.2 | - | 0 |
| S. aureus | 7.5 ± 0.00 | 14.25 ± 1.0 | 17.5 ± 0.16 | 19.5 ± 0.71 | - | 21.0 ± 0.5 | 0 |
| MDR Bacteria | Methanolic Extract (µg/mL) | ||
|---|---|---|---|
| MIC | MBC | MBC/MIC | |
| K. pneumoniae | 100 | 200 | 4 |
| E. hormaechei | 100 | >200 | ND |
| E. ludwigii | 100 | 200 | 4 |
| E. coli | 50 | 100 | 2 |
| P. aeruginosa | 50 | >200 | ND |
| S. aureus | 50 | 100 | 2 |
| Time/min | Solvent A (%) | Solvent B (%) |
|---|---|---|
| 0–22 | 90 | 10 |
| 22–32 | 50 | 50 |
| 32–40 | 100 | 0 |
| 40–44 | 100 | 0 |
| 44–50 | 10 | 90 |
| 50 | 10 | 90 |
| Age (Years) | Female | Male |
|---|---|---|
| 15–24 | 32 | 70 |
| 25–45 | 57 | 80 |
Disclaimer/Publisher’s Note: The statements, opinions and data contained in all publications are solely those of the individual author(s) and contributor(s) and not of MDPI and/or the editor(s). MDPI and/or the editor(s) disclaim responsibility for any injury to people or property resulting from any ideas, methods, instructions or products referred to in the content. |
© 2025 by the authors. Licensee MDPI, Basel, Switzerland. This article is an open access article distributed under the terms and conditions of the Creative Commons Attribution (CC BY) license (https://creativecommons.org/licenses/by/4.0/).
Share and Cite
Bahri, F.; Boussena, A.; Szumny, A.; Bahri, Y.; Bahri, E.-M.; Figiel, A.; Juszczyk, P. Use of Haloxylon scoparium Against Multidrug-Resistant Bacteria from Urinary Tract Infections. Antibiotics 2025, 14, 471. https://doi.org/10.3390/antibiotics14050471
Bahri F, Boussena A, Szumny A, Bahri Y, Bahri E-M, Figiel A, Juszczyk P. Use of Haloxylon scoparium Against Multidrug-Resistant Bacteria from Urinary Tract Infections. Antibiotics. 2025; 14(5):471. https://doi.org/10.3390/antibiotics14050471
Chicago/Turabian StyleBahri, Fouad, Abdelhadi Boussena, Antoni Szumny, Youcef Bahri, El-Mokhtar Bahri, Adam Figiel, and Piotr Juszczyk. 2025. "Use of Haloxylon scoparium Against Multidrug-Resistant Bacteria from Urinary Tract Infections" Antibiotics 14, no. 5: 471. https://doi.org/10.3390/antibiotics14050471
APA StyleBahri, F., Boussena, A., Szumny, A., Bahri, Y., Bahri, E.-M., Figiel, A., & Juszczyk, P. (2025). Use of Haloxylon scoparium Against Multidrug-Resistant Bacteria from Urinary Tract Infections. Antibiotics, 14(5), 471. https://doi.org/10.3390/antibiotics14050471

